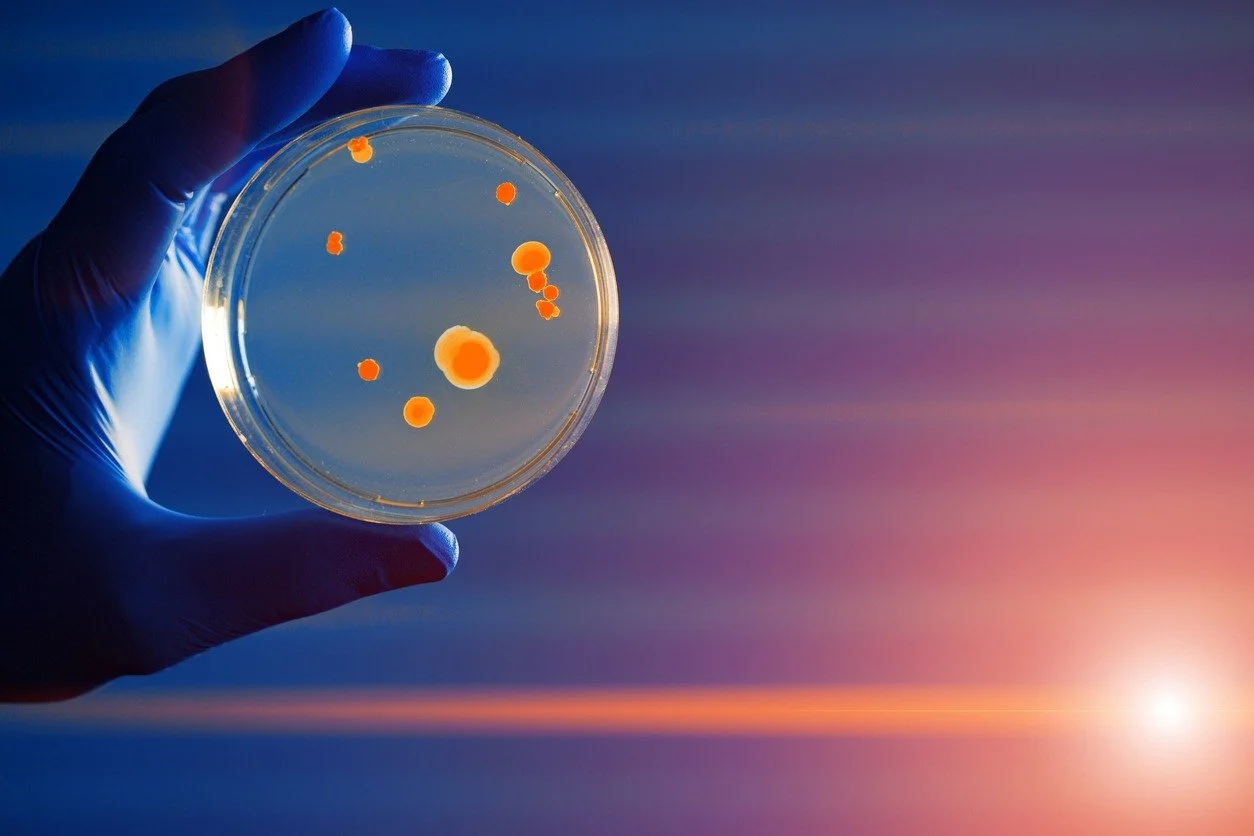

News & Updates
Check out our latest news, updates, and opportunities.
News & Updates
News & Updates
iiCON and SME partner reach key stage in development of new Pneumoccal Disease Vaccine
The Infection Innovation Consortium: iiCON and partners have launched the first human challenge trial for a new vaccine for pneumococcal disease – marking a key milestone in a collaborative global project that is offering new hope in the fight against the disease.
Top property professional Colin Sinclair appointed to head up high-powered investment task force.
ONE of the region’s most influential property professionals has been appointed to head up the Invest Liverpool City Region (ILCR) Partnership Taskforce.
Innovation Investment Fortnight to showcase billions of pounds of Liverpool City Region opportunities
Running from May 12-23, Innovation Investment Fortnight (IIF) will feature at least 20 events covering topics ranging from the city region’s world-leading life sciences innovation to maritime, space, AI and sports science.
£10m funding for AI-powered robotic labs that will accelerate new treatments for deadly infections
New AI-powered, robotic labs that will accelerate development of new treatments for deadly diseases are to be built in Liverpool after £10m Innovation Zone funding was agreed.
New £10m robotic labs investment for iiCON
New £10m robotic labs investment for iiCON in plans to ‘supercharge’ Liverpool life sciences.
Drones, swabs and robotic dogs feature in latest Future Innovators Programme tour
The Future Innovators Programme encourages young people to learn about the innovation, science and technology career opportunities available in KQ Liverpool, with an aim of creating tangible aspirations.
iiCON strengthens team following ongoing growth
The Infection Innovation Consortium: iiCON has bolstered its core team, welcoming a cohort of new starters to support operations following strong growth.
New UK partnership and research fund aims to tackle infectious diseases
Liverpool School of Tropical Medicine and self-funded charitable medical research organisation, LifeArc, are partnering to launch a new Translational Development Fund to help tackle infectious diseases.
iiCON supports 11 new products to market in first 18 months
iiCON: Infection Innovation Consortium has supported 11 new products to market since launching in September 2020, with a further 16 in the development pipeline.
LSTM spinout iiDiagnostics launched
iiDiagnostics will enable industry engagement and commercial access to the world-leading diagnostics R&D capability and facilities at LSTM.
LSTM reveal plans for infection innovation centre
Plans have been revealed for a new multi-million-pound centre located in Knowledge Quarter Liverpool.
Dr Fiona Marston becomes LSTM’s Entrepreneur in Residence
Dr Fiona Marston is to become LSTM’s Entrepreneur in Residence after being awarded a place on the Royal Society’s scheme for 2021.
LSTM Launches New Transposon Registry
LSTM has launched a new Transposon Registry, which will serve as a repository of information on all bacterial transposons for the scientific community.
LSTM Signs Partnership With Medical Charity
LSTM and the Humanitarian Conflict Response Institute (HCRI) of the University of Manchester have signed a global partnership with a medical charity.